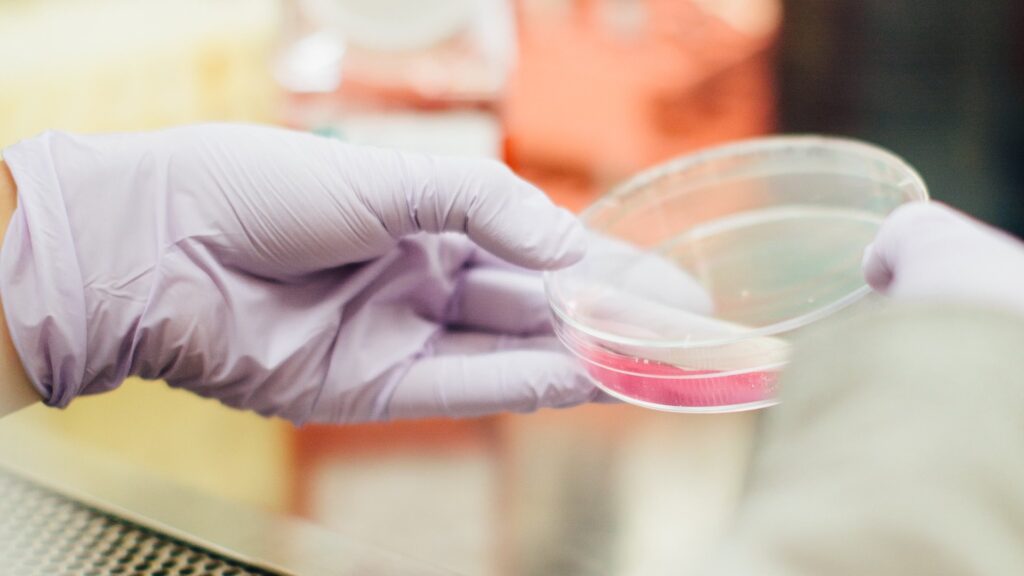

Ученые из Университета Копенгагена обнаружили, что болезнь Паркинсона может быть вызвана нарушениями митохондриальной ДНК. Исследование было опубликовано в журнале Nature. Об этом сообщает Bizmedia.kz.
Ученые из Копенгагена обнаружили связь между нарушениями митохондриальной ДНК и болезнью Паркинсона
Ученые из Копенгагенского университета сделали открытие, связывающее возникновение болезни Паркинсона с нарушениями в митохондриальной ДНК. Исследование было опубликовано в журнале Nature. Болезнь Паркинсона — это прогрессирующее заболевание центральной нервной системы, которое проявляется замедлением движений, дрожанием и нарушением рефлексов. Причины этой болезни до сих пор неизвестны.
Датские специалисты выдвинули гипотезу о том, что повреждение митохондриальной ДНК может быть причиной заболевания. Митохондриальная ДНК находится в митохондриях — крошечных органеллах, присутствующих в большинстве клеток. Они играют важную роль в процессе выработки энергии, объединяя питательные вещества из глюкозы и жиров, поступающих с пищей. Большое количество митохондрий находится в клетках, которым требуется большое количество энергии, включая мышечные волокна и мозг.
На основе полученных данных исследователи предполагают, что болезнь Паркинсона может быть вызвана дефектными митохондриями, образующимися в результате мутации митохондриальных генов. Эти поврежденные митохондрии активно размножаются в нервных клетках головного мозга, способствуя их дегенерации.
В настоящее время ученые стремятся обнаружить биомаркеры — вещества, с помощью которых можно изучить изменения в организме, указывающие на повреждения митохондриальной ДНК. Скорее всего, их можно будет обнаружить с помощью анализа крови.